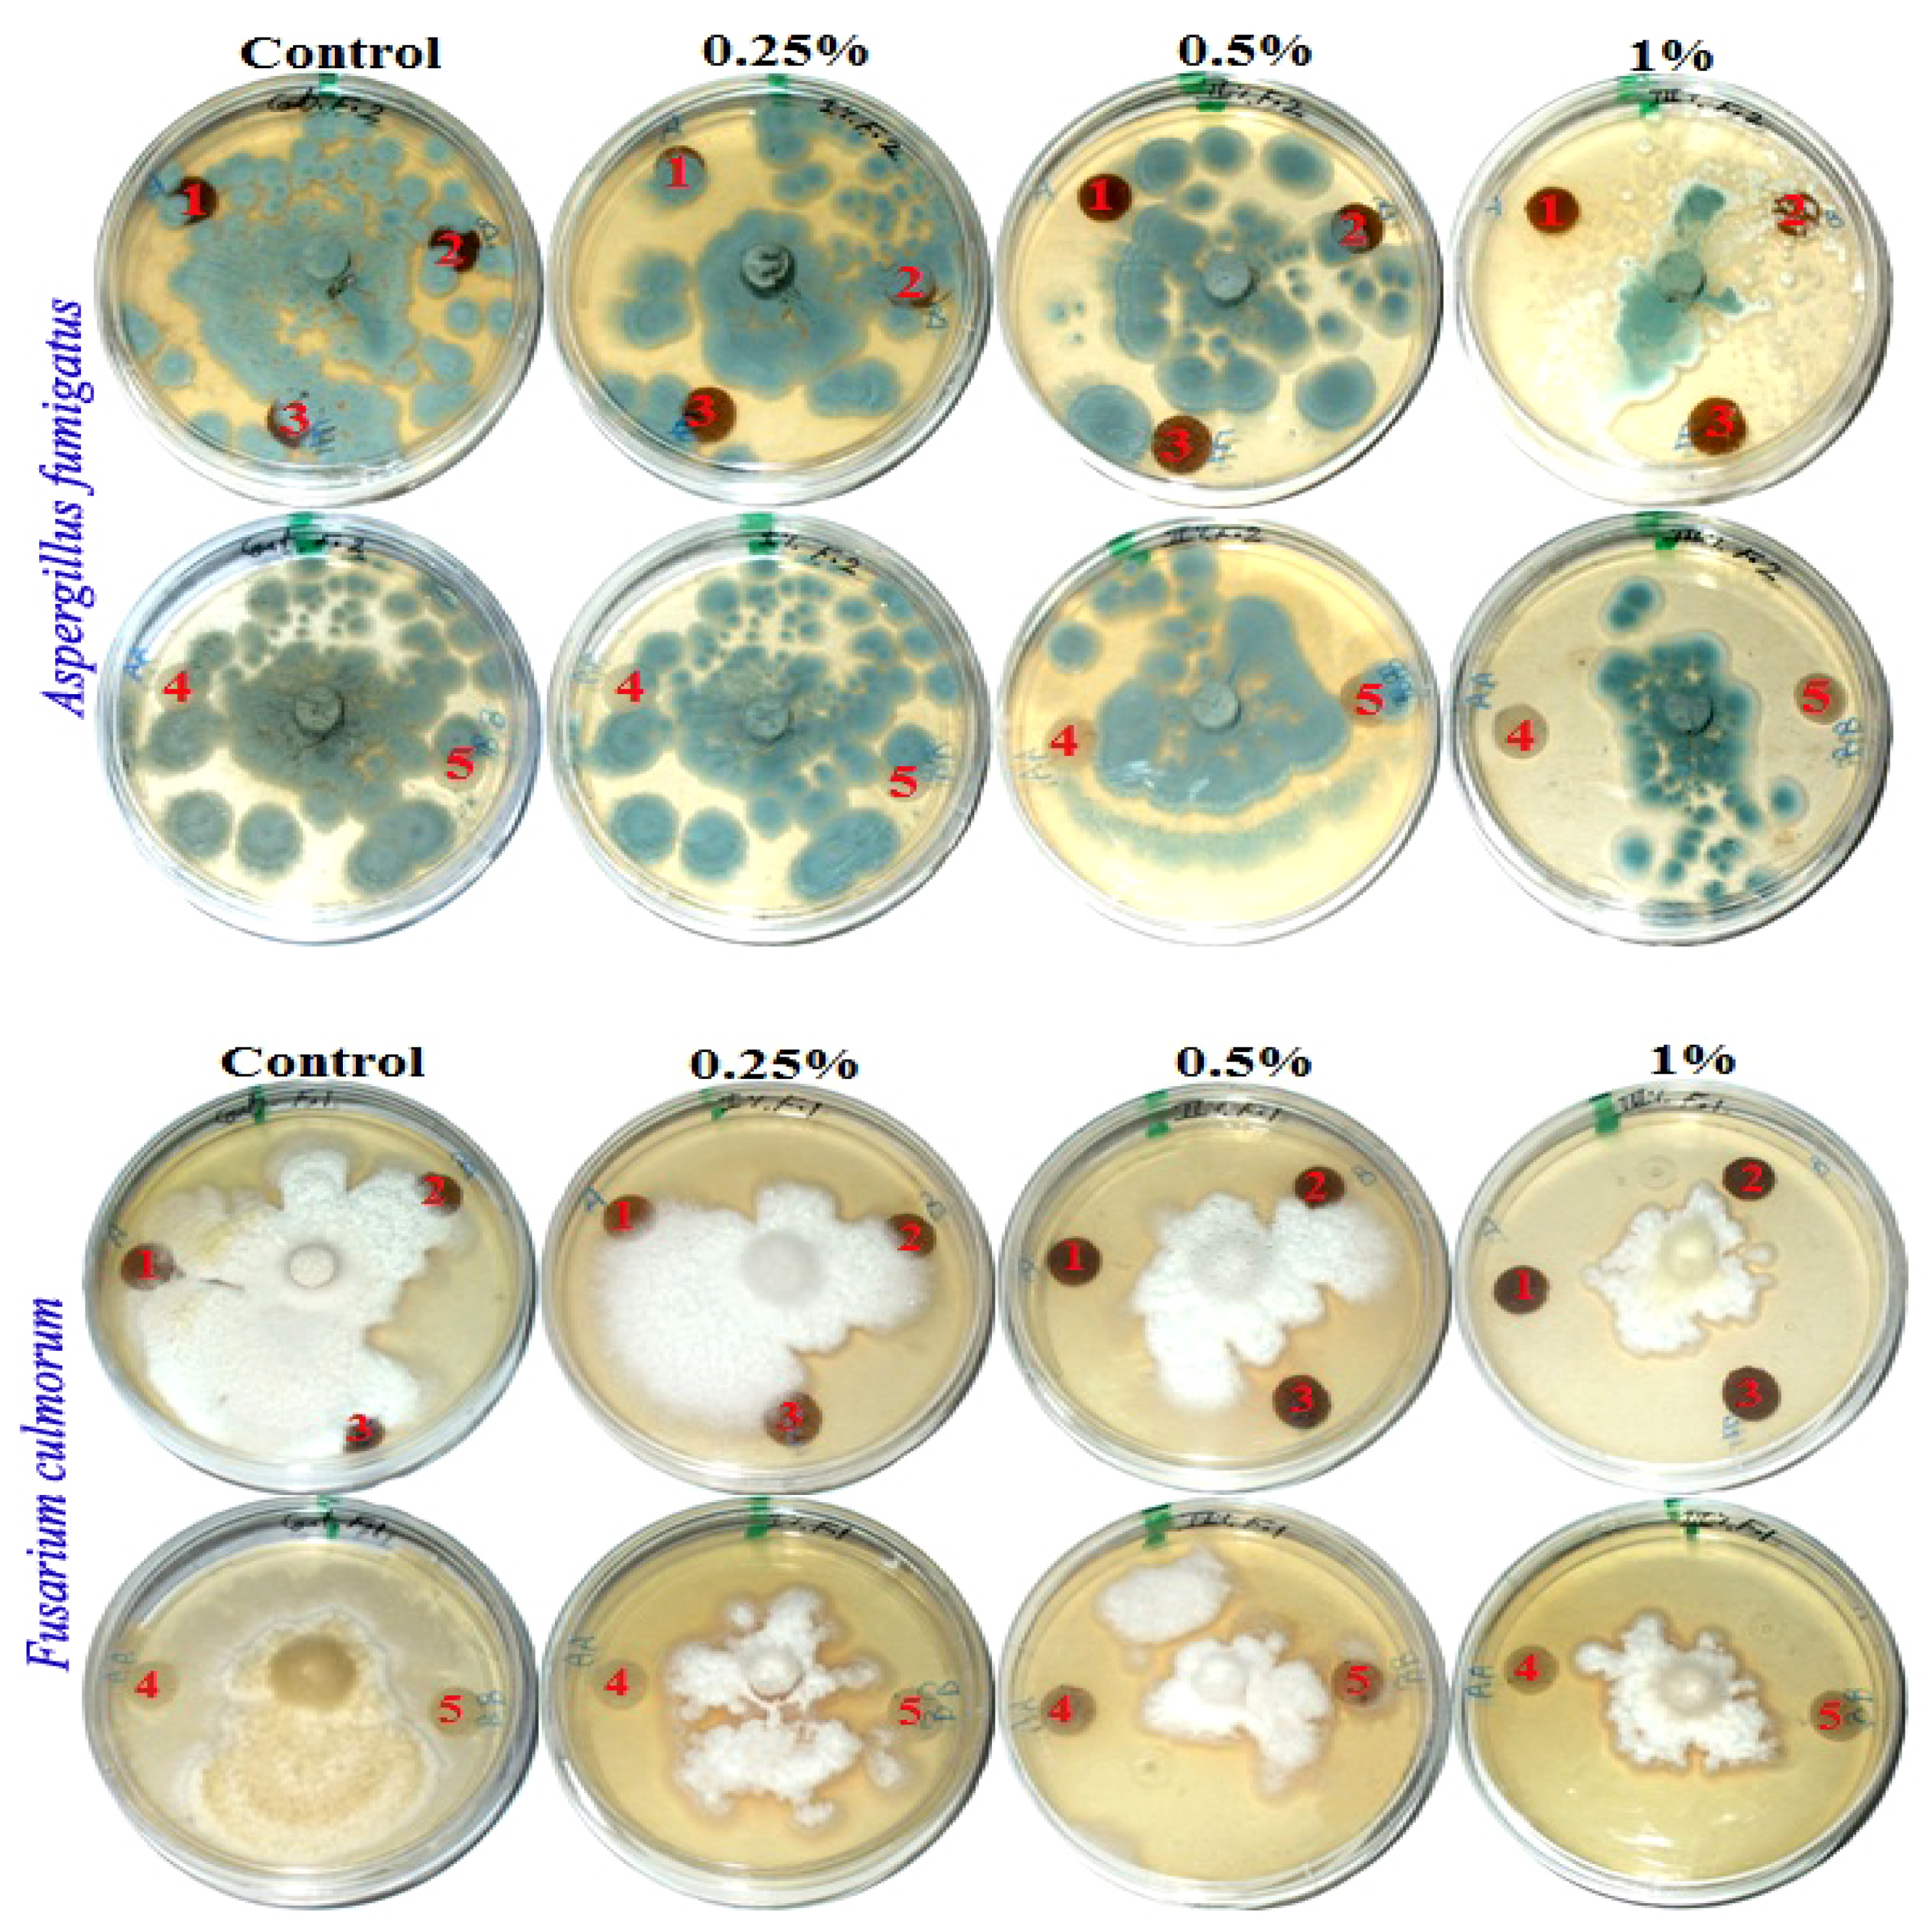
Polymers 13 02012 g002a
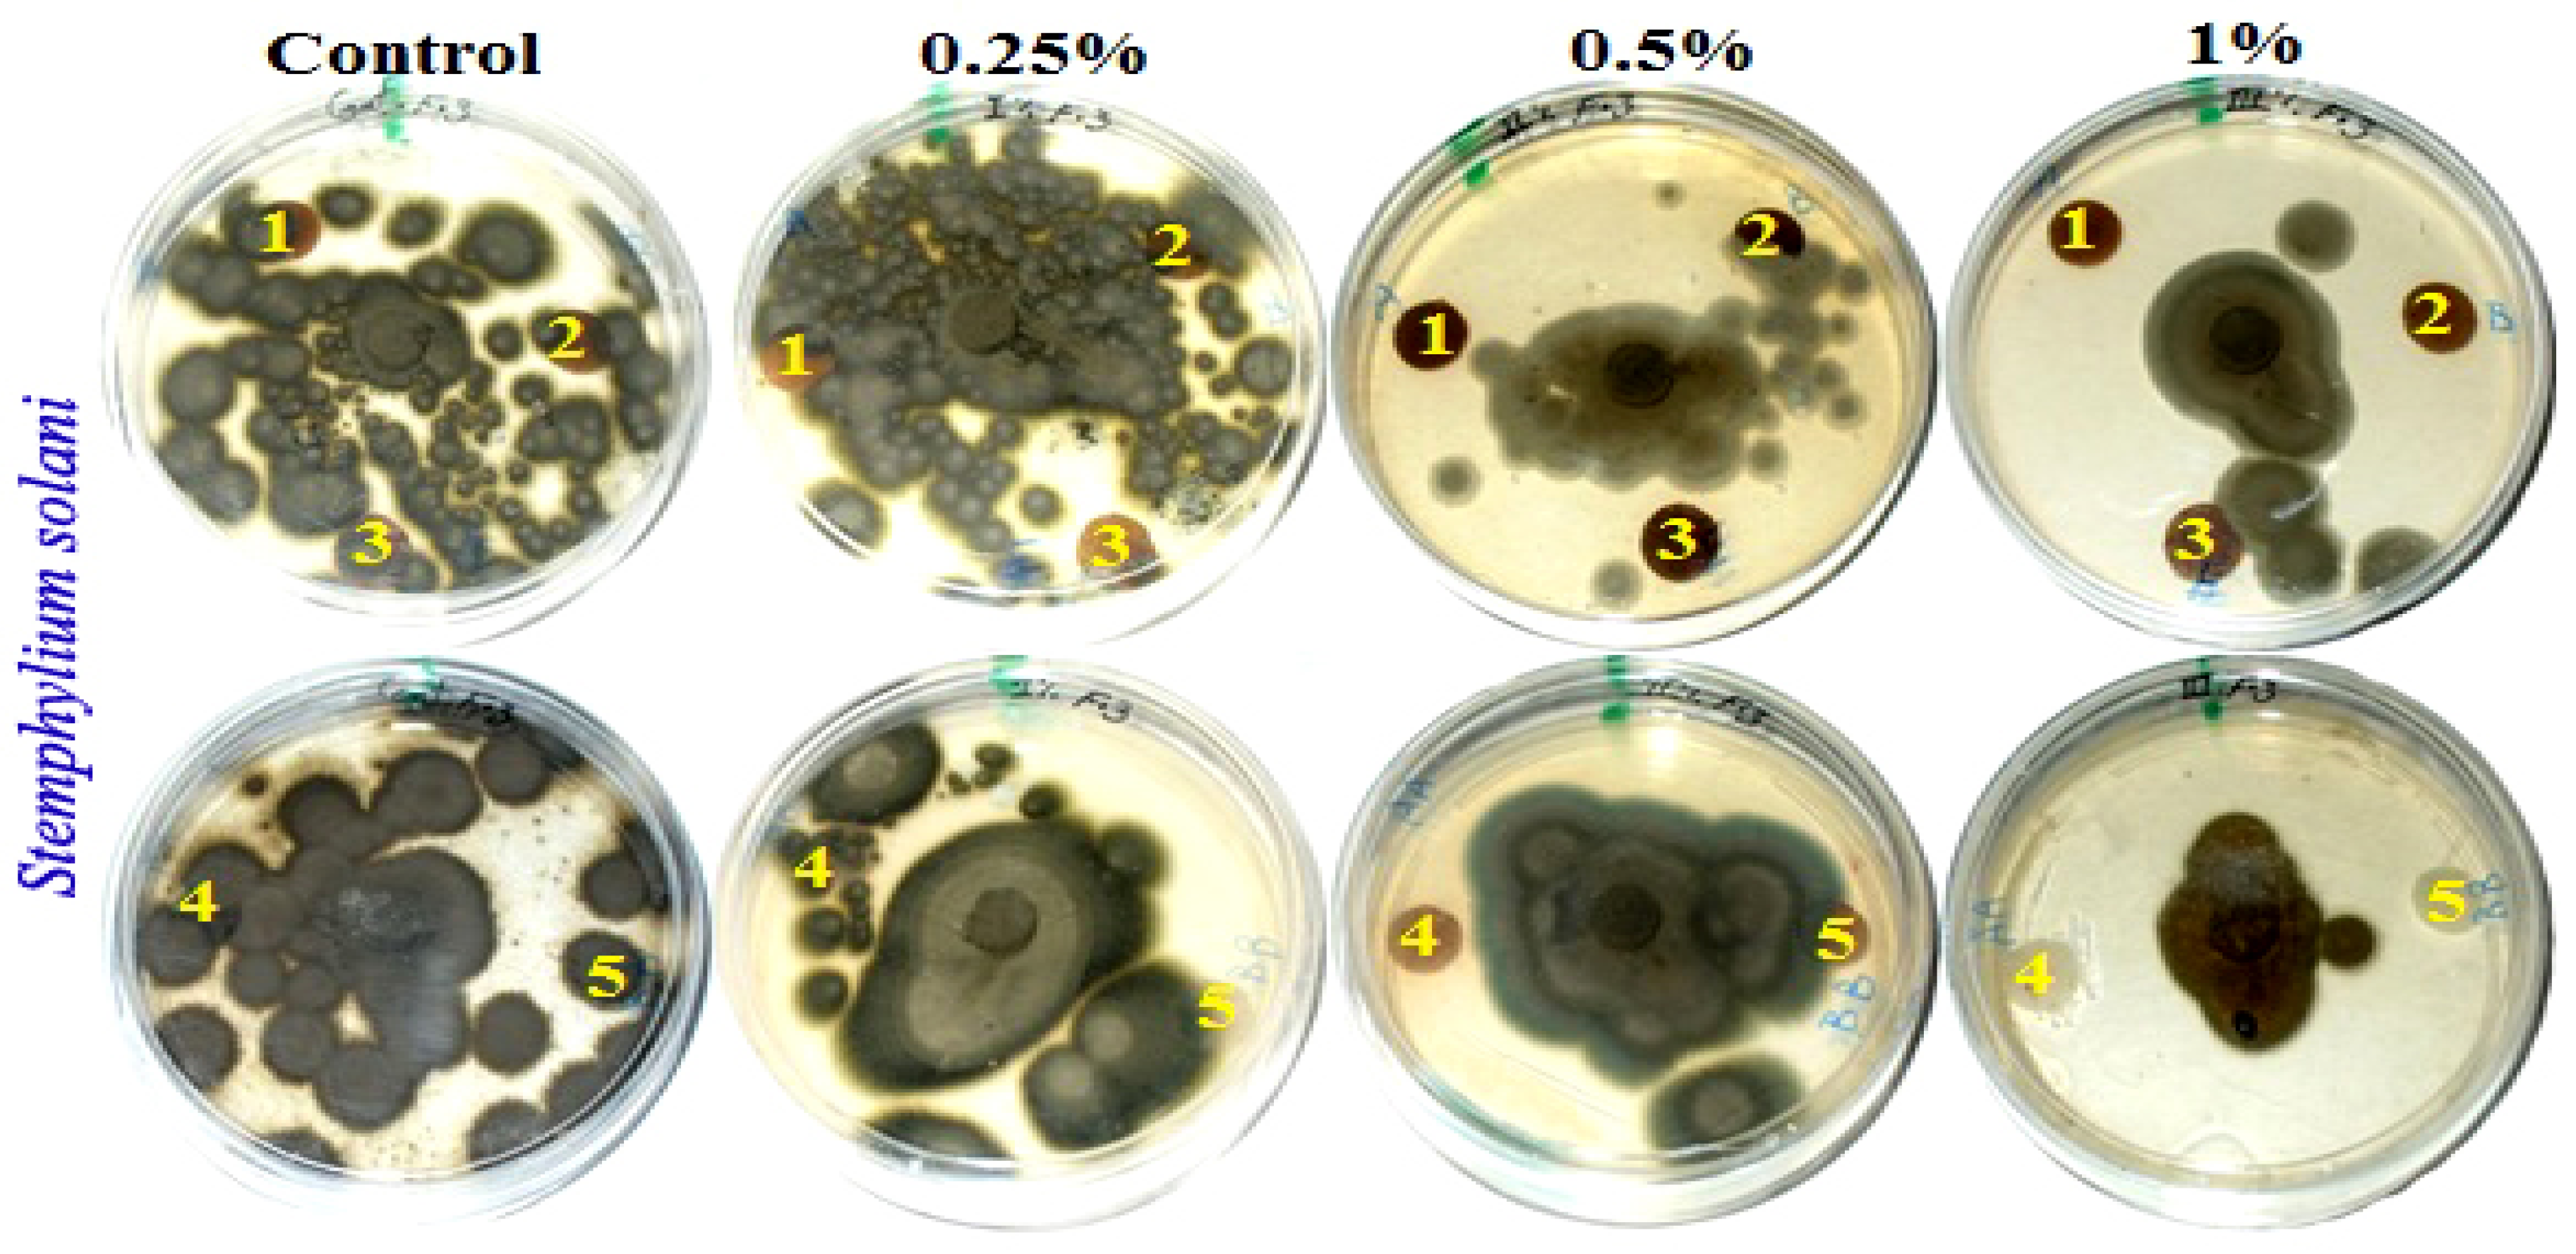
Polymers 13 02012 g002b

Abstract
The main objective of this work was to evaluate pulp produced by kraft cooking for wood materials (WMT) (Bougainvillea spectabilis, Ficus altissima, and F. elastica) and non-wood materials (NWMT) (Sorghum bicolor and Zea mays stalks) and to study the fungal activity of handsheets treated with Melia azedarach heartwood extract (MAHE) solutions. Through the aforementioned analyses, the ideal cooking conditions were determined for each raw material based on the lignin percentage present. After cooking, pulp showed a decrease in the Kappa number produced from WMT, ranging from 16 to 17. This was in contrast with NWMT, which had Kappa numbers ranging from 31 to 35. A difference in the optical properties of the pulp produced from WMT was also observed (18 to 29%) compared with pulp produced from NWMT (32.66 to 35.35%). As for the evaluation of the mechanical properties, the tensile index of the pulp ranged from 30.5 to 40 N·m/g for WMT and from 44.33 to 47.43 N·m/g for NWMT; the tear index ranged from 1.66 to 2.55 mN·m2/g for WMT and from 4.75 to 5.87 mN·m2/g for NWMT; and the burst index ranged from 2.35 to 2.85 kPa·m2/g for WMT and from 3.92 to 4.76 kPa·m2/g for NWMT. Finally, the double fold number was 3 compared with that of pulp produced from pulp, which showed good values ranging from 36 to 55. In the SEM examination, sheets produced from treated handsheets with extract from MAHE showed no growth of Aspergillus fumigatus over paper discs manufactured from B. speclabilis pulp wood. Pulp paper produced from Z. mays and S. bicolor stalks was treated with 1% MAHE, while pulp paper from F. elastica was treated with 0.50% and 1% MAHE. With the addition of 0.5 or 1% MAHE, Fusarium culmorum showed no increase in growth over the paper manufactured from B. speclabilis, F. altissima, F. elastica and Zea mays pulps with visual inhibition zones found. There was almost no growth of S. solani in paper discs manufactured from pulps treated with 1% MAHE. This is probably due to the phytochemical compounds present in the extract. The HPLC analysis of MAHE identified p-hydroxybenzoic acid, caffeine, rutin, chlorogenic acid, benzoic acid, quinol, and quercetin as the main compounds, and these were present in concentrations of 3966.88, 1032.67, 834.13, 767.81, 660.64, 594.86, and 460.36 mg/Kg extract, respectively. Additionally, due to the importance of making paper from agricultural waste (stalks of S. bicolor and Z. mays), the development of sorghum and corn with high biomass is suggested.
1. Introduction
There are shortages of conventional raw materials that are used for the production of pulp and paper products. Together with the increasing demand for paper worldwide, this has led to a focus on the use of non-wood fibers or forestry residues as sources of raw materials. There are various lignocellulosic materials that can be produced from agricultural residues from harvesting and pruning operations that can be used for this purpose [1]. Specifically, the most important agricultural residues, due to their abundance, are cereal straw, sunflower stalks, bagasse, waste from the palm oil industry, vine shoots, cotton stems, olives, waste from orange and peach tree pruning, waste from vegetable crops, sorghum, abaca, sisal, jute, hemp, kenaf, flax, linen, bamboo, and papyrus sheets [2,3,4,5,6,7,8,9,10]. Non-wood raw materials are characterized by a low density and more porous structure, with a lower lignin content in most cases. Thus, they require less energy and chemicals to separate fibers during pulp production than wood species do [11]. It was estimated that 8% of commercially produced pulp is non-wood pulp [12].
Several non-wood materials, such as flax plants, dhaincha (Sesbania bispinosa), jute stick (Corchorus capsularis), sugarcane bagasse, cotton stalk, rice straw, wheatgrass, smooth bromegrass, switchgrass (Panicum virgatum), Miscanthus giganteus, and bamboo, have been studied to assess their suitability for the production of pulp and paper [7,8,9,10,13,14,15,16,17,18,19,20,21,22]. For example, sorghum stalks (Sorghum bicolor) can be used as an alternative source for pulp production. They are characterized by short fibers and a high proportion of fine fibers, so they can be used to produce low luminosity printing and kraft paper [12]. Additionally, it was stated that the production of sorghum stalk pulp has a lower requirement for chemicals than woody pulp production, so it is a suitable method for the production of quality paper [12].
Previous studies have focused on the properties of pulp and paper produced from Zea mays and S. bicolor stalks and have shown them to have promising values in terms of mechanical properties, such as the tensile index, burst index, tear index, burst index, and double fold number [15,16,22,23,24,25].
Ficus trees, belonging to the Moraceae family, could be suitable for use in pulp and paper production. The structural parameters of wood from 12 Nigerian species of Ficus have been shown to be suitable for use in pulp and paper production [26] due to, for example, the low vessel count and size of F. exasperata wood [27] or the high content of cellulose polymers in Opuntia ficus-indica [28].
Most previous studies in this area have shown that the properties of paper produced from softwood species are better than those of paper produced from hardwood species [29]. Studies from Egypt characterized the papermaking properties of woods from trees such as Populus alba, Eucalyptus camaldulensis, Meryta sinclairii, Acacia nilotica, and Cupressus sempervirens. A. nilotica wood was found to produce a significantly superior net pulp yield [29,30], and P. alba wood was shown to produce high-quality paper [29]. Furthermore, the small-diameter logs or branches resulting from the process of pruning fruit or timber trees have been studied in terms of their suitability for the production of pulp and paper [30,31,32,33,34,35].
The kraft and soda–anthraquinone pulping methods are used for hardwood species, for example, for the pulping of P. tremuloides clones [36]. For agriculture residues, kraft pulping is used for wheat or barley straw [37,38] and for pruning olive tree wood [31,35]. It is also used for Leucaena leucocephala, Cytisus proliferus, and Hesperaloe funifera [39,40], Cynara cardunculuns L. [41], vine shoots [42], and kenaf (Hibiscus cannabinus and H. sabdariffa) [43].
Natural products, such as phenolics, flavonoids, and essential oils, which can be extracted from medicinal and aromatic plants are used as mediated agents for the green synthesis of nanoparticle materials as well as in adhesives to produce bio-based adhesives or cellulose film, have shown promising antimicrobial activity [44,45,46,47,48,49] and may enhance pulp fibers [50,51].
Different materials have been used to enhance the fungal resistance properties of pulp and paper. For example, Pinus rigida ground wood has been used as an additive to linen fiber pulp and has shown resistance against Aspergillus terreus, A. niger, and Fusarium culmorum [7]. Further, nanomaterials have been added to papyrus sheets to guard against A. flavus, A. niger, and Colletotrichum gloeosporioides [8]. Paper discs made from E. camaldulensis and M. sinclairii branchwood pulp and treated with oily extracts from Melia azedarach fruits, Sinapis alba seeds, and Magnolia grandiflora leaves (in concentrations of 3% and 5%) showed no growth of A. niger and A. terreus [30].
Melia azedarach, or the chinaberry tree, belongs to the mahogany family, Meliaceae. It is a deciduous tree with high-quality, medium-density wood colored from light brown to dark red. The wood has many uses, for example, in construction, furniture, plywood, and boxes [52,53,54]. Heartwood was found to be resistant to white and brown rot fungi [55]. Its extracts showed the presence of bakayanin, bakalactone, and tannin compounds [56], and its stem extracts showed insecticidal activity against Earias vittella, Helicoverpa armigera, and Plutella xylostella [57]. These activities are mostly related to the presence of active chemical compounds, such as phenolic, flavonoid, and limonoid compounds [58]. The technological processing of wood produces a large quantity of waste in the form of saw-dust and shavings that, in the present study, were subsequently used as a source for the extraction of natural chemical compounds.
The present study aimed to evaluate the pulp paper parameters of hardwood species (Bougainvillea spectabilis, Ficus altissima, and F. elastica), sorghum (Sorghum bicolor), and corn (Zea mays) stalks using advanced techniques involving the application of Melia azedarach heartwood extract to show the enhanced ability of paper discs to act against the growth of three types of mold fungi. This involved the use of SEM.
2. Materials and Methods
2.1. Preparation of Raw Biomass Materials
Wood from Bougainvillea spectabilis, Ficus altissima, and F. elastica, as well as stalks from Sorghum bicolor and Zea mays, were collected from Alexandria city in Egypt. Raw materials from Bougainvillea spectabilis, F. altissima, and F. elastica were debarked, chipped, and fractionated using a knife mill, screened, and then cut to small sizes ranging from 2 to 3 cm and homogenized in single lots. Depithed S. bicolor and Z. mays stalks were cut to chips of sizes ranging from 2.5 to 3 cm (Figure 1). All raw materials were washed with water to remove extraneous dirt, sand, nodes, and other foreign materials. The washed materials were air-dried and then stored in polyethylene bags under dry conditions for use in experimental work.

Figure 1.
Kraft pulping of wood species and non-wood materials. (A) F. altissima; (B) F. elastica; (C) B. spectabilis; (D) Z. mays; and (E) S. bicolor.
2.2. Chemical Analysis of the Raw Materials
Approximately 20 g raw material samples were ground into powder in a Culatti micro impact mill type grinder (Model MFC, CZ13; ZENITH, Zurich, Germany) with a 1 mm screen, fraction passed through a 40-mesh and retained on +60-mesh to be used for chemical analysis. Chemical characterization of raw materials was conducted as per TAPPI standard test methods. Tests carried out included solvent extraction, measurement of the alcohol–benzene solubility (1:2 v/v), and determination of the acid-insoluble lignin, holocellulose, and ash contents using the following methods: TAPPI T204 CM-07 [59], TAPPI T222 OM-15 [60], TAPPI T249-09 [61], and TAPPI T211 OM-16 [62]. All summative chemical analysis results are reported as the percentage of the initial raw biomass material.
2.3. Kraft Pulping Procedure Used for Wood Species
Two-hundred-gram oven-dried wood samples from each of B. spectabilis, F. altissima, and F. elastica were swelled for one day, before being filtrated and impregnated in sodium hydroxide 8% solution for 1 h at 85 °C. Then, they were washed with hot water at 70 °C. Kraft pulping was conducted in a stainless-steel vessel with a 3 L capacity under rotation in an oil bath. The pulping conditions were as follows for all raw wood materials: 17% active alkalinity, 20% sodium oxidate to produce sulfidity, a temperature of 180 °C, a reaction time of 180 min, and a liquor ratio (liquid to wood ratio) of 10:1. The solid residue was defibrated and washed with hot and cold water until reaching a neutral pH. The resultant pulp was screened on a valley flat screen with 0.25 mm slots. All woody species were pulped in triplicate. The yield, residual alkali, kappa number, freeness of pulp (Schopper–Riegler, °SR), ash content in pulp, and the opacity and brightness of pulp were determined by the following TAPPI standard methods: T210 CM-03 [63], T625 CM-14 [64], T236 om-13 [65], ISO 5267-1 [66], T211 OM-16 [62], T425 OM-16 [67], and T452 OM-18 [68].
2.4. Kraft Pulping of Corn and Sorghum Stalks
Two-hundred-gram samples of oven-dried raw material from corn and sorghum stalks were swelled for one day, filtrated, and washed several times with hot water. Kraft pulping was conducted in a stainless-steel vessel with a 2 L capacity under rotation in an oil bath for the pulping of corn and sorghum stalks. The following parameters were used: 11% active alkalinity, a temperature of 160 °C, a reaction time of 35 min, and a liquor ratio (liquid to stems ratio) of 10:1. The solid residue was defibrated and washed with hot water and cold water until reaching a neutral pH. The resultant pulp was screened in a valley flat screen with 0.25 mm slots. The pulp collection and conventional bleaching stages were carried out with sodium hydroxide and sodium hypochlorite, and excess distilled water was used for washing between stages (Figure 1). The yield, residual alkali, kappa number, freeness of pulp (Schopper–Riegler, °SR), ash content in pulp, and opacity and brightness of pulp were determined using the following TAPPI standard methods: T210 CM-03 [63], T625 cm-14 [64], T236 OM-13 [65], ISO 5267-1 [66], T211 OM-16 [62], T425 OM-16 [67], and T452 OM-18 [68].
2.5. Handsheet Formation and Paper Testing
Handsheet formation was used to prepare standard pulp sheets (200 cm²) for physical testing according to T 220 sp-16 [69]. The samples were diluted to 2000 mL (1.2%) with water and disintegrated at 3000 rpm. After that, the stock was diluted to 0.15% with water at a temperature of 22 °C. To make the sheets, the handsheet formation machine was used to turn on water, and the container was filled with water. Then, 500 mL of stock was added to gain the required consistency and rapidly allow water to move down the cylinder (in 3 ± 1 s) using rotary oscillation for stirring. Immediately after the water had drained from the handsheet, the container was opened, and the sheet was picked with blotting paper, before being dried and weighed to calculate the stock concentration.
After constructing a standard sheet for physical testing (1.22 g), the wet test sheet was placed on a clean mirror-polished plate and covered with another dried blotter ready to receive the next couch blotter and sheet. After that, the sheets were placed in the press template to conduct the first round of pressing at 50 psi for 5 min. Then, the polished plates were removed after first pressing them and placing them on another side, and 50 psi was applied for 2.5 min. Subsequently, the sheets attached to the plate were removed from the press template and placed in drying rings. The sheets were dried according to the standard conditions specified in T 402 sp-08 [70] (23 ± 1 °C and 50 ± 2% RH humidity) until equilibrium moisture was achieved, allowing the sheets to become fully dried in the ring before removing them from the plates. Pulp from standard paper sheet samples (200 cm²) and a grammage of about 60 g/m2 was prepared for the determination of dry strength properties according to T 205 sp-02 [71].
The samples were conditioned at 50 ± 2% RH and 23 ± 1 °C according to T 402 sp-08 [70] for at least 4 h. Handsheets were made and their strength properties were tested according to T 220 sp-16 [69]. For the handsheets, the properties tested were the tensile index (T 494 OM-13) [72], tear index (T414 om-12) [73], burst index (T 403 OM-15) [74], and double fold number (T 511 OM-13) [75]. Analysis of the physical strength of pulp was performed according to TAPPI standard methods with standard 60 g/m2 sheets.
2.6. Antifungal Activity of Handsheets Treated with Melia azedarach Heartwood Extract
Melia azedarach heartwood (MAH) was ground to powder using a small laboratory mill. About 150 g of powdered wood was extracted by soaking in 200 mL of methanol solvent for three days [76]. The extract was then filtered through filter paper (Whatman no.1) and concentrated by evaporating the solvent to leave the M. azedarach heartwood extract (MAHE). The chemical compounds of the extract were analyzed using Agilent 1260 Infinity HPLC Series (Agilent, Santa Clara, CA, USA), as described in our previous studies [77,78,79,80,81,82,83]. Standard HPLC-grade pyrogallol, quinol, gallic acid, catechol, p-hydroxybenzoic acid, caffeine, chlorogenic acid, vanillic acid, caffeic acid, syringic acid, vanillin, p-coumaric acid, ferulic acid, benzoic acid, rutin (quercetin-3-O-rutinoside), ellagic acid, o-coumaric acid, salicylic acid, cinnamic acid, myricetin (3,5,7,3′,4′,5′-hexahydroxyflavone), quercetin, rosmarinic acid, naringenin, and kaempferol were purchased from Sigma-Aldrich (St. Louis, MO, USA).
Before carrying out the antifungal activity method, the handsheets were sterilized, and three concentrations of MAHE (1, 0.5, and 0.25%) were prepared through dilution in dimethyl sulfoxide (Sigma-Aldrich, Darmstadt, Germany) (10% DMSO). The extract solutions were added to handsheets by spraying onto the surface of the paper after most of the water had been removed during sheet formation. Discs (0.9 cm in diameter) from the handsheets treated with the extract solutions were prepared and put over a PDA medium. Then, they were inoculated separately with a 9 mm mycelial disc of the pathogenic fungi from a seven-day-old colony of each of the following three fungal strains: Fusarium culmorum Fcu761 (acc# MH355954), Aspergillus fumigatus Afu694 (acc# MH355959), and Stemphylium solani Ssol382 (acc# MH355956). These were compared with discs treated with 10% DMSO as controls. Each treatment was tested in triplicate. After 14 days of incubation at 26 ± 1 °C, the inhibition zones and growth on discs (in mm) were calculated.
2.7. SEM Examination of Paper Sheets Treated with MAHE and Inoculated with Fungi
Examination by scanning electron microscope (SEM) was used to observe the extent of fungal growth on paper discs taken from wood treated and untreated with MAHE and inoculated with each of the three fungi using the JFC-1100E ion sputtering device (model JEOL/MP, JSM-IT200 Series, Tokyo, Japan) at 8 kV [7,8,30].
2.8. Statistical Analysis
The chemical properties of the raw materials, the pulp properties, and the mechanical and optical characteristics of B. spectabilis, F. altissima, F. elastica, Z. mays, and S. bicolor were statistically analyzed using one-way ANOVA [84].
3. Results and Discussion
3.1. Chemical Analysis of the Raw Materials
Table 1 shows the highly significant differences (P < 0.01) between the wood and non-wood raw materials in terms of the chemical parameters of the raw materials (benzene–alcohol extractives, lignin, holocellulose, and ash content).
Table 1.
ANOVA test for the chemical properties of raw materials.
The results for the chemical compounds of the raw materials (Table 2) show that benzene–alcohol extracts, lignin, holocellulose, and ash content were 1.73–13.16%, 16.66–42.33%, 53.37–63.40%, and 1.66–6.73%, respectively. The holocellulose content in S. bicolor stalks was in accordance with the range of values reported in the literature: 71.0% [16], 67.2% [23], 68.0% from depithed extraction [85], 61.6% extracted with 1% NaOH [85], 69.0% from depithed extraction [86], and 61.6% extracted with 1% NaOH [86]. The average pulp yield from S. bicolor stalks was 45%, and the average kappa number was 14–18 when 16–20% sodium (NaOH) and a 1.5 h cooking time at 160 °C were used [12]. The holocellulose content in Z. mays (62.33%) and S. bicolor (63.40%) stalks was higher than that in lotus leaf stalks (53.8%) [87].
Table 2.
Chemical properties of raw materials.
The lignin content in wood from B. spectabilis (35.87%), F. altissima (41.33%), and F. elastica (42.33%) was much higher than that in hardwood species (25–35%) [19], Eucalyptus globulus (23.9%), E. nitens (25.5%), E. urograndis (26.6%), red oak (27.7%), cottonwood (21.5%), sweet gum (27.2%), acacia (26.8%), birch (22.8%), red alder (24.4%), maple (25.9%) [33], and the poplar cultivar ‘Hybrid 275’ (18.0%) [20]. Additionally, it was higher than that in softwood species such as European larch (31.2%), birch (26.6%), and pine (26.4%), as well as some other non-wood materials such as tall wheatgrass (13.6%), smooth bromegrass (13.7%), tall fescue (14.0%), switchgrass (17.4%), and Miscanthus giganteus (17.8%) [20].
The lignin content in S. bicolor (16.66%) and Z. mays (18.66%) stalks was in the range of that in non-wood monocotyledon species (9–20%) [19]. The lignin content in S. bicolor was equal to that found in depithed and extracted samples (16.1%) [16] and lower than that found in tropical hardwoods (25–35%) [19]. The lignin content in both S. bicolor and Z. mays was lower than in bamboo (26%) [19], rice hulls (20.44%) [88], and lotus leaf stalks (25.4%) [87], and higher than that in smooth bromegrass (13.7%) and tall fescue (14.0%) [20]. The content was also partially in the range of that reported for switchgrass (17.4%), Miscanthus giganteus (17.8%) [20], sugar beet (17.67%) [88], and S. bicolor stalks (17.4%) [23]. The ash content was high, especially in S. bicolor, but others were within the range of tropical hardwood (1 to 3%) [89].
Among the studied materials, it can be seen from the above results that Z. mays and S. bicolor stalks had the highest amounts of benzene–alcohol extract and holocellulose. F. altissima and F. elastica wood showed the highest lignin content, while S. bicolor stalks, followed by B. spectabilis wood, had the highest ash content.
3.2. Chemical Analysis of the Produced Pulp
All pulp properties studied (ash content, residual alkali, Kappa number, screen pulp yield, freeness (Schopper–Riegler, (°SR)) were observed to have highly significant differences (P < 0.01) among the studied wood and non-wood raw materials (Table 3). In terms of the pulp properties (Table 4), the ash content, residual alkali, Kappa number, screen pulp yield, freeness (°SR), and rejects were 1.76–13.53%, 1.23–7.75 g/L, 16.66–35.66, 35.33–41.00%, 24.33–33.33 °SR, and 0.13–4.23%, respectively.
Table 3.
ANOVA test for the chemical properties of the produced pulp.
Table 4.
Chemical properties of the pulps yielded.
The Kappa numbers for B. spectabilis (35.66), F. altissima (31.33), and Ficus elastica (35.33) pulps were higher than those of E. globulus (17) [34], poplar cultivar ‘Hybrid 275’ (20.63) [20], E. camaldulensis (24), and M. sinclairii pulps (18) [30]. Additionally, the Kappa numbers recorded for Z. mays and S. bicolor pulps were comparable with that recorded for E. globulus pulp (17) [34] and lower than that for bamboo (Gigantochloa scortechinii) (14.2–18.1) [90]. Kraft pulping of bamboo chips was observed to produce a Kappa number of 17.4 [91], which is nearly comparable with our results for Z. mays (16.66) and S. bicolor (17.66). Additionally, the value was lower than those for some softwood pulps such as European larch (56.83), birch (23.38), and pine (42.22) [20]. Furthermore, the Kappa numbers for Z. mays and S. bicolor were slightly higher than those for other non-wood materials such as tall wheatgrass (12.25%), smooth bromegrass (14.42), tall fescue (12.71%), switchgrass (13.71), and Miscanthus giganteus (14.31) [20]. Results from the Soda-AQ pulping of rice straw showed Kappa numbers ranging from 12.3 to 26 depending on the mesh size [18].
It can be summarized that pulp produced from S. bicolor stalks, F. altissima wood, B. spectabilis/F. elastica wood, B. spectabilis wood, and Z. mays stalks showed the highest ash%, residual alkali g/L, screen pulp yield, freeness (°SR), and rejects (%) values, respectively.
3.3. Mechanical and Optical Properties of the Produced Handsheets
Table 5 shows that all the mechanical and optical properties (tensile index N·m/g, tear index mN·m2/g, burst index kPa·m2/g, double fold number, opacity %, and brightness %) among the studied handsheets from wood and non-wood raw materials were statistically highly significant effects (P < 0.01).
Table 5.
ANOVA analysis of mechanical and optical properties of the produced handsheets.
Table 6 shows that the highest tensile index was observed with handsheets produced from Z. mays (47.43 N·m/g), followed by those produced from S. bicolor (44.33 N·m/g) and F. elastica (40 N·m/g). The highest tear index was found in handsheets produced from Z. mays (5.87 mN·m2/g), followed those produced from S. bicolor (4.75 mN·m2/g). Additionally, handsheets produced from pulps of Z. mays and S. bicolor showed the highest burst index and double fold number with values of 4.76 kPa·m2/g and 55 and 3.92 kPa·m2/g and 36.33, respectively. The highest opacity percentages were observed for handsheets produced from F. elastica wood (99.8%) and F. altissima wood (99.1%), while the lowest value was found with handsheets produced from Z. mays stalks (93.56%). Handsheets produced from Z. mays and S. bicolor stalks were observed to have the highest brightness values: 35.33% and 32.66%, respectively. The burst index (3.92 kPa·m2/g) of the S. bicolor handsheet was higher than that reported for S. bicolor x S. bicolor var. sudanense pulp grown in Turkey under optimum conditions (3.56 kPa·m2/g) [16]. The burst index ranged from 0.16 to 0.29 kPa·m2/g in sweet sorghum bagasse [23] and was equal as reported to the values reported in papers that produced pulp from Populus tremula via the kraft method (3.85 kPa·m2/g) [32]. The unrefined unbleached pulp from Z. mays stalks had a tensile index, burst index, tear index, and double fold number of 49.1 N·m/g, 3.80 kN/g, 7.53 mN·m2/g, and 86, respectively [22]. In another study, a tensile index of 9.1 N·m/g and a tear index (1.2 N·m/g) were reported for pulp produced from corn stalks [15]. The tensile index of corn stalk pulp ranged from 52 (unbeaten state) to 77.0 N·m/g (beaten state) [24] and from 1.83 to 4.39 N·m/g [23]. For our raw materials, the tear index values were similar to those of other materials such as the oil palm leaf (1.8 N·m2/g), date palm rachis (4.4 N·m2/g), and palmyra fruit (1.1 N·m2/g), while our results for the tensile index were higher than that obtained for the oil palm leaf (7.9 N·m/g) and similar to those obtained for the date palm rachis (1.09 N·m/g) and palmyra fruit (13.8 N·m/g) [15].
Table 6.
Mechanical and optical properties of the produced handsheets.
The burst index value measured for handsheets from Z. mays pulp (4.76 kPa·m2/g) was lower than that for corn stalk (6.6 kPa·m2/g) but higher than that for date palm rachis (1.32 kPa·m2/g) and oil palm leaf (0.9 kPa·m2/g) [25]. In the folding test, handsheets from corn stalks produced a value of 55 N, while another study reported a value of 2.5 Nm and compared this with oil palm leaf (1.23 Nm) and oil palm (1.9 Nm) [25].
The paper sheets obtained from olive tree pruning pulp were produced with different degrees of refining and were characterized by their stretch index, burst index, and tear index. All paper sheets reached a stretch index value of between 33 and 39 kNm/kg, a burst index of between 1.5 and 2 kN/g, and a tear index of 0.7–2.5 N·m2/g. A high refining degree was not used (<45 °SR) [92,93]. Pulp from empty fruit bunches from oil palm showed a burst index value of 4.17 kN/g and a tear index of 7.20 mN·m2/g, for a degree of refining of 47.5 °SR, acceptable for the formation of handsheets [2]. Pulp paper made from sunflower seeds had a burst index of 1.15 kN/g and a tear index of 2.04 mN·m2/g [13]. Paulownia wood pulp was used to produce paper sheets with a brightness of 27.4% ISO, a tensile index of 28.87 N·m/g, a burst index of 1.22 kPa.m2/g, and a tear index of 1.23 kN·m2/g [94]. H. funifera pulp showed a tensile index of 83.6 N·m/g, a burst index of 7.34 kN/g, and a tear index of 3.20 mN·m2/g [14]. The tensile index of degummed whole cotton stalk pulp ranged from 23.40 to 40.54 N·m/g, and the tear index ranged from 3.95 mN·m2/g to 4.52 mN·m2/g [17]. The mechanical properties of handsheets produced from Z. mays and S. bicolor stalk pulps were comparable to those from rice straw: a burst index of 2.43–5.34 kPa·m2/g, folding endurance of 35–173, a tear index of 6.49–7.49 mN·m2/g, and a tensile index of 38.0–55.2 N·m/g, depending on the mesh size [18]. Another study measured the tensile index (N·m/g), burst index (kPa·m2/g), and tear index (mN·m2/g) of pulp from the European larch (90.0, 7.8, 8.0), birch (105.8, 7.2, 3.8), pine (103.9, 6.9, 6.1), poplar cultivar ‘Hybrid 275’ (109.0, 8.3, 3.8%), tall wheatgrass (81.6, 6.4, 3.2%), smooth bromegrass (89.0, 7.1, 4.4), tall fescue (85.7, 6.2, 4.4%), switchgrass (68.9, 4.3, 3.7), and Miscanthus giganteus (73.4, 4.4, 3.7), respectively [20].
Handsheets from Z. mays and S. bicolor stalks had the highest values for mechanical properties. Additionally, the folding endurance strength showed that paper from those materials could achieve higher folding numbers than those from the hardwood species investigated in this study. Other studies revealed that Ficus species with large amounts of parenchyma have a significantly lower ratio of fibers to non-fibrous tissue [26], leading to a lower yield of pulp and a problem of binding resulting from the ‘fine fibers’ [95].
3.4. Antifungal Activity and SEM Examination of MAHE-Treated Handsheets
Figure 2 presents the antifungal activity of the produced handsheets that were previously treated with MAHE against three mold fungi (Aspergillus fumigatus, Fusarium culmorum and Stemphylium solani). The fungal inhibition zones (in mm) and the fungal growth on the treated discs are presented in Table 7.

Figure 2.
Visual observation of the antifungal activity of paper sheets treated with MAHE; paper sheet samples from pulp produced from (1) B. speclabilis; (2) F. altissima; (3) F. elastica; (4) Z. mays; and (5) S. bicolor.
Table 7.
Visual screenings of the antifungal activity of paper sheets treated with MAHE against the growth of Aspergillus fumigatus, Fusarium culmorum, and Stemphylium solani 14 days after inoculation.
Fourteen days after incubation, and with an increase in the extract concentration, the inhibition or suppression of fungal growth occurred. According to visual observations and compared with the control treatments, no fungal growth of A. fumigatus occurred on paper discs of B. speclabilis pulp wood or pulp paper produced from Z. mays and S. bicolor stalks and treated with 1% MAHE, or pulp paper produced from F. elastica and treated with 0.50% and 1% of MAHE. At MAHE concentrations of 0.50% and 1%, F. culmorum showed no growth on paper discs manufactured from B. speclabilis, F. altissima, F. elastica, and Z. mays pulp, with visual inhibition zones found (Table 7), while no growth was found following treatment with 1% MAHE on paper discs made from S. bicolor pulp. Furthermore, nearly no growth of S. solani was found on paper discs manufactured from the raw materials treated with 1% MAHE, and inhibition zones were found.
SEM examinations of (Figure 3, Figure 4, Figure 5, Figure 6, Figure 7, Figure 8, Figure 9, Figure 10, Figure 11 and Figure 12) the paper discs made from the studied materials, treated with MAHE, and inoculated with the three mold fungi were conducted to observe and show how this MAHE acts against the growth of the studied fungi by suppressing their hyphal and mycelial growth. Figure 3 shows huge, dense fungal mycelia growth (FMG) of F. culmorum on the paper discs made from untreated samples (control, 10% DMSO). Additionally, with the application of 0.25% MAHE, dense FMG was still found for F. culmorum (Figure 4). With 0.5% MAHE, the FMG of F. culmorum was suppressed and the hyphal mass growth was reduced, as shown in Figure 5a,b. Examination of F. elastica pulp wood treated with 1% MAHE under SEM found no FMG of F. culmorum and fibers were clearly shown (Figure 5c).

Figure 3.
SEM images of the paper sheets manufactured from pulp of (a) Bougainvillea speclabilis, (b) Ficus altissima, (c) Ficus elastica, (d) Zea mays, and (e) Sorghum bicolor treated with 10% DMSO (control) and inoculated with F. culmorum. Arrows refer to dense growth of fungal mycelia in the sample fibers.
Figure 4.
SEM images of the paper sheets manufactured from pulp of (a) Bougainvillea speclabilis, (b) Ficus altissima, (c) Ficus elastica, and (d) Sorghum bicolor treated with 0.25% MAHE and inoculated with F. culmorum. Arrows refer to dense growth of fungal mycelia based on the concentration of the extract and the type of paper sheet pulp.
Figure 5.
SEM images of the paper sheets manufactured from (a) Ficus altissima, (b) Sorghum bicolor treated with 0.5% MAHE, and (c) Ficus elastica treated with 1% MAHE and inoculated with F. culmorum. Arrows refer to low growth of fungal mycelia based on the concentration of the extract and the type of paper sheet pulp.
Figure 6.
SEM images of paper sheets from (a) B. speclabilis, (b) F altissima, (c) F. elastica, (d) Z. mays, and (e) S. bicolor treated with 10% DMSO (control) and inoculated with A. fumigatus. Arrows refer to dense growth of fungal mycelia in sample fibers.
Figure 7.
SEM images of paper sheets manufactured from pulps of (a) B. speclabilis, (b) F. altissima, and (c) F. elastica treated with 0.25% MAHE and inoculated with A. fumigatus. Arrows refer to dense growth of fungal mycelia based on the concentration of the extract and the type of paper sheet pulp.

Figure 8.
SEM images of paper sheets manufactured from pulps of (a) B. speclabilis, (b) F. altissima, and (c) F. elastica treated with 0.5% MAHE and inoculated with A. fumigatus. Arrows refer to low growth of fungal mycelia based on the concentration of the extract and the type of paper sheet pulp.
Figure 9.
SEM images of the paper sheets manufactured from (a) B. speclabilis, (b) F. altissima, and (c) F. elastica treated with 10% DMSO (control) and inoculated with S. solani. Arrows refer to dense growth of fungal mycelia in sample fibers.
Figure 10.
SEM images of paper sheets manufactured from pulps of (a) B. speclabilis, (b) F. altissima, and (c) F. elastica treated with 0.25% MAHE and inoculated with S. solani. Arrows refer to dense growth of fungal mycelia based on the concentration of the extract and the type of paper sheet pulp.
Figure 11.
SEM images of paper sheets manufactured from (a) B. speclabilis and (b) F. altissima treated with 0.5% MAHE and inoculated with S. solani. Arrows refer to low and no growth of fungal mycelia based on the concentration of the extract and the type of paper sheet pulp.
Figure 12.
SEM images of the paper sheets manufactured from (a) B. speclabilis, (b) F. altissima, and (c) F. elastica treated with 1% MAHE and inoculated with S. solani. Arrows refer to low growth of fungal mycelia based on the concentration of the extract and the type of paper sheet pulp.
Figure 6 shows the dense FMG of A. fumigatus on paper discs treated with 10% DMSO (control) made from B. speclabilis (Figure 6a), Ficus altissima (Figure 6b), F. elastica (Figure 6c), Z. mays (Figure 6d), and S. bicolor pulp (Figure 6e). The FMG of A. fumigatus began to decrease following treatment of the paper discs with 0.25% MAHE, as shown in Figure 7. Following treatment with 0.5% MAHE, paper discs made from pulps of B. speclabilis (Figure 8a), F. altissima (Figure 8b), and F. elastica (Figure 8c) showed low FMG of A. fumigatus, as the extract suppressed the FMG of A. fumigatus, and the fibers were more clearly shown. In the SEM examination, FMG of S. solani was clearly shown, with dense growth over the fibers of untreated (control 10% DMSO) handsheets made from B. speclabilis (Figure 9a), F. altissima (Figure 9b), and F. elastica pulp (Figure 9c).
FMG was reduced in the treated handsheets treated with 0.25% Z. album extract, but growth was still dense, as S. solani mycelia were found over and between the fibers (Figure 10). Low or even no FMG of S. solani was found when the handsheets were treated with 0.5% MAHE, and weak interconnections of hyphae with the fiber structure of the paper were found (Figure 11). The FMG of S. solani was nearly suppressed (Figure 12a,c) or completely suppressed (Figure 12b) following the application of 1% MAHE to the produced handsheets.
These results are in agreement with those of previous studies [96]. Papyrus strips pretreated with natural extracts were enhanced in terms of the technological (mechanical and optical) and antifungal (against A. flavus, A. niger, and C. gloeosporioides) properties of the produced papyrus sheets [8]. In a previous study, the novel combination of chitosan or Paraloid B-72 c with nanoparticles of Ag, ZnO, or cellulose was used to produce antifungal handsheets. The huge growth of A. flavus, A. terreus, and S. solani that was observed on handsheets produced with pulp with additives of chitosan and Paraloid B-72 at 4% was compared with pulp without additives [9]. The addition of powdered plant materials in the three concentrations was less or not effective at preventing the growth of the three tested fungi—A. terreus, F. culmorum, and A. niger—but treated pulp from P. rigida wood had some defense against A. terreus and A. niger at all tested concentrations [7].
3.5. Testing of Phytochemical Compounds of MAHE by HPLC
The previous results clearly show that by increasing the concentration of MAHE, the suppression of fungal growth occurs. Additionally, some treatments resulted in no fungal growth. These results could be related to the phytochemical compounds present in the extract. Table 8 presents the chemical compounds presented in MAHE. The main compounds (in mg/kg) are p-hydroxybenzoic acid (3966.88), caffeine (1032.67), rutin (quercetin 3-O-rutinoside) (834.13), chlorogenic acid (767.81), benzoic acid (660.64), quinol (594.86), quercetin (460.36), vanillic acid (366.13), myricetin (302.404), and caffeic acid (130.97). Figure 13 shows the chromatogram peaks that were used to separate the chemical compounds in MAHE.
Table 8.
Chemical compounds in Melia azedarach heartwood extract.
Figure 13.
HPLC Fingerprint profile of phytochemicals present in Melia azedarach heartwood extract.
From different parts of M. azedarach (Meliaceae family), phenolic compounds p-coumaric acid, vanillic acid, gallic acid, caffeic acid, ferulic acid, protocatechin, p-hydroxybenzoic acid, chlorogenic acid, rutin, and salicylic acid were identified. The ingredient components active against Meloidogyne incognita were identified as p-coumaric acid and p-hydroxybenzoic acid [97]. At a wavelength of 280 nm, the main phenolic compounds in the leaves of Melia azedarach were found to be rutin, quercetin-3-O-neohesperidoside, kaempferol-3-O-rutinoside, feruloylglucaric acid, and feruloylquinic acid derivative [98]. Extracts from different parts of M. azedarach exhibited fungistatic activity against A. flavus, Diaporthe phaseolorum var. meridionales, F. oxysporum, F. solani, F. verticillioides, and Sclerotinia sclerotiorum, where vanillin, 4-hydroxy-3-methoxycinnamaldehyde and (±)-pinoresinol were found to be the main compounds [99]. Additionally, rutin, kaempferol 3-O-robinobioside, and kaempferol 3-O-rutinoside were isolated from water extract of M. azedarach leaves [100]. Gallic acid and (–) epicatechin were isolated from bark extract [101]. Flavonoids naringenin, quercetin, myricetin, and dihydromyricetin were isolated from Soymida febrifuga wood extract (Meliaceae family) [102].
4. Conclusions
Cellulosic fibers from wood and non-wood raw materials are a renewable material used for production in the pulp and paper industries. In this study, fibers from woody materials (Bougainvillea spectabilis, Ficus altissima, and F. elastica) and stalks of Sorghum bicolor and Zea mays were used for the production of pulp paper. They were treated with MAHE at concentrations of 0.25%, 0.50%, and 1% and then inoculated separately with the mold fungi Fusarium culmorum, Aspergillus fumigatus, and Stemphylium solani. A chemical analysis of raw materials was conducted (wood of Bougainvillea spectabilis, Ficus altissima, F. elastica and stalks of Sorghum bicolor and Zea mays), and the concentration of benzene–alcohol extracts ranged from 1.7 to 4.87% in wood fibers and 5.53 to 13.1% in non-wood fibers. The lignin content ranged from 35.37 to 42.33% in wood fibers and 16.66 to 18.88% in non-wood fibers. The percentage of holocellulose was 35.87 to 42.33% in wood fibers and 62.3 to 63.4% in non-wood fibers. Finally, the ash percentage ranged from 1.66 to 3.43% in wood fibers and 2.73 to 6.73 % in non-wood materials. The mechanical properties of pulp handsheets made from Z. mays and S. bicolor stalks were much more favorable than those made from hardwoods under the conditions of this study. Additionally, the folding endurance strength showed that paper made from those materials can have a greater folding number than that for paper made from hardwood species. Treatment with MAHE was associated with an improvement in antifungal properties, with visual inhibition zones found and confirmed with SEM examination. The results of the SEM examination of MAHE-treated handsheets inoculated with the tested fungi showed that by increasing the MAHE concentration, the suppression of fungal growth increased. Additionally, with a MAHE concentration of 1%, the three tested fungi showed low or no growth of fungal mycelia depending on the MAHE concentration and the type of handsheet pulp. This indicates the potential for the use of M. azedarach heartwood extract to produce pulp paper in an ecofriendly way.
Author Contributions
Conceptualization, M.Z.M.S.; Formal analysis, M.Z.M.S., W.A.A.A.E., A.S.T. and Y.G.D.F.; Funding acquisition, S.S.A., A.M.E.-S. and R.Y.G.; Investigation, S.S.A., A.M.E.-S. and R.Y.G.; Methodology, M.Z.M.S., W.A.A.A.E., A.S.T. and Y.G.D.F.; Resources, W.A.A.A.E., A.S.T. and Y.G.D.F.; Software, S.S.A. and R.Y.G.; Supervision, A.M.E.-S.; Validation, R.Y.G.; Visualization, W.A.A.A.E., A.S.T. and A.M.E.-S.; Writing—original draft, M.Z.M.S., S.S.A., W.A.A.A.E., Ayman S. Taha, Y.G.D.F., A.M.E.-S. and R.Y.G.; Writing—review and editing, M.Z.M.S., W.A.A.A.E., A.S.T. and Y.G.D.F. All authors have read and agreed to the published version of the manuscript.
Funding
The current work was funded by Taif University Researchers Supporting Project number (TURSP-2020/38), Taif University, Taif, Saudi Arabia.
Institutional Review Board Statement
Not applicable.
Informed Consent Statement
Not applicable.
Data Availability Statement
Not applicable.
Acknowledgments
The current work was funded by Taif University Researchers Supporting Project number (TURSP-2020/38), Taif University, Taif, Saudi Arabia.
Conflicts of Interest
The authors declare no conflict of interest.
References
- Eugenio, M.E.; Ibarra, D.; Martín-Sampedro, R.; Espinosa, E.; Bascón, I.; Rodríguez, A. Alternative raw materials for pulp and paper production in the concept of a lignocellulosic biorefinery. IntechOpen, 2019; pp. 1–26. Available online: https://www.intechopen.com/books/cellulose/alternative-raw-materials-for-pulp-and-paper-production-in-the-concept-of-a-lignocellulosic-biorefin (accessed on 15 May 2021). [CrossRef]
- Jiménez, L.; Serrano, L.; Rodríguez, A.; Sánchez, R. Soda-anthraquinone pulping of palm oil empty fruit bunches and beating of the resulting pulp. Bioresour. Technol. 2009, 100, 1262–1267. [Google Scholar] [CrossRef] [PubMed]
- Marques, G.; del Río, J.C.; Gutiérrez, A. Lipophilic extractives from several nonwoody lignocellulosic crops (flax, hemp, sisal, abaca) and their fate during alkaline pulping and TCF/ECF bleaching. Bioresour. Technol. 2010, 101, 260–267. [Google Scholar] [CrossRef] [PubMed]
- Miao, C.; Hui, L.-F.; Liu, Z.; Tang, X. Evaluation of Hemp Root Bast as a New Material for Papermaking. BioResources 2014, 9, 132–142. [Google Scholar] [CrossRef]
- Fahmy, Y.; Fahmy, T.Y.; Mobarak, F.; El-Sakhawy, M.; Fadl, M. Agricultural residues (wastes) for manufacture of paper, board, and miscellaneous products: Background overview and future prospects. Int. J. ChemTech Res. 2017, 10, 424–448. [Google Scholar]
- Chen, Z.; Zhang, H.; He, Z.; Zhang, L.; Yue, X. Bamboo as an Emerging Resource for Worldwide Pulping and Papermaking. BioResources 2018, 14, 3–5. [Google Scholar] [CrossRef]
- Taha, A.S.; Abo Elgat, W.A.; Salem, M.Z.M.; Ali, H.M.; Fares, Y.G.E.; Elshikh, M.S. Impact of Some Plant Source Additives on Enhancing the Properties and Antifungal Activities of Pulp Made from Linen Fibers. BioResources 2019, 14, 6025–6046. [Google Scholar]
- Taha, A.S.; Salem, M.Z.M.; Abo Elgat, W.A.A.; Ali, H.M.; Hatamleh, A.A.; Abdel-Salam, E.M. Assessment of the Impact of Different Treatments on the Technological and Antifungal Properties of Papyrus (Cyperus Papyrus L.) Sheets. Materials 2019, 12, 620. [Google Scholar] [CrossRef]
- Abo Elgat, W.A.A.; Taha, A.S.; Böhm, M.; Vejmelková, E.; Mohamed, W.S.; Fares, Y.G.D.; Salem, M.Z.M. Evaluation of the Mechanical, Physical, and Anti-Fungal Properties of Flax Laboratory Papersheets with the Nanoparticles Treatment. Materials 2020, 13, 363. [Google Scholar] [CrossRef]
- Fares, Y.G.D.; Taha, A.S.; Abo Elgat, W.A.A.; Salem, M.Z.M.; Al-Huqail, A.A.; Ali, H.M. Ecologically Friendly Modified Green Liquor Method for Enhancing the Technological Properties of Sugarcane Bagasse (Saccharum officinarum L.) Pulp. BioResources 2020, 15, 7458–7474. [Google Scholar] [CrossRef]
- Ashori, A. Nonwood Fibers—A Potential Source of Raw Material in Papermaking. Polym.-Plast. Technol. Eng. 2006, 45, 1133–1136. [Google Scholar] [CrossRef]
- Patil, J.V.; Appaji, C.; Rao, S.V.; Mathur, R.M.; Bist, V.; Lal Preeti, S. High Bio-mass Sorghum (Sorghum bicolor)—An Alternate Raw Material for Pulp and Paper Making in India. IPPTA Q. J. Indian Pulp Pap. Tech. Assoc. 2011, 23, 161–165. [Google Scholar]
- Caparrós, S.; Ariza, J.; López, F.; Nacimiento, J.A.; Garrote, G.; Jiménez, L. Hydrothermal treatment and ethanol pulping of sunflower stalks. Bioresour. Technol. 2008, 99, 1368–1372. [Google Scholar] [CrossRef]
- Sánchez, R.; Rodríguez, A.; Navarro, E.; Requejo, A.; Jiménez, L. Integrated utilization of the main components of Hesperaloe funifera. Biochem. Eng. J. 2011, 56, 130–136. [Google Scholar] [CrossRef]
- Daud, Z.; Hatta, M.Z.M.; Awang, H. Oil Palm Leaf and Corn Stalk—Mechanical Properties and Surface Characterization. Procedia—Soc. Behav. Sci. 2015, 195, 2047–2050. [Google Scholar] [CrossRef][Green Version]
- Gençer, A.; Şahin, M. Identifying the conditions required for the NaOH method for producing pulp and paper from sorghum grown in Turkey. BioResources 2015, 10, 2850–2858. [Google Scholar] [CrossRef]
- Zhao, Y.-M.; Liu, Z.; Hui, L.-F.; Li, Q.; Li, X.-S.; Huang, Y.-J. Degumming Pretreatment with Sodium Hydroxide and Sodium Oxalate in the Process of Whole Cotton Stalk APMP Pulping. BioResources 2015, 10, 2913–2925. [Google Scholar] [CrossRef]
- Shao, S.; Wu, C.; Chen, K. Refining, dewatering, and paper properties of soda-anthraquinone (soda/AQ) pulp from rice straw. BioResources 2017, 12, 4867–4880. [Google Scholar] [CrossRef]
- Lourenço, A.; Pereira, H. Compositional variability of lignin in biomass, Lignin, Trends and Applications; InTech: London, UK, 2018; Chapter 3; Volume 10, pp. 65–98. [Google Scholar]
- Przybysz, K.; Małachowska, E.; Martyniak, D.; Boruszewski, P.; Iłowska, J.; Kalinowska, H.; Przybysz, P. Yield of pulp, dimensional properties of fibers, and properties of paper produced from fast growing trees and grasses. BioResources 2018, 13, 1372–1387. [Google Scholar] [CrossRef]
- Sutradhar, S.; Sarkar, M.; Nayeem, J.; Jahan, M.S.; Tian, C. Potassium hydroxide pulping of four non-woods. Bangladesh J. Sci. Ind. Res. 2018, 53, 1–6. [Google Scholar] [CrossRef]
- Mishra, O.P.; Tripathi, S.K.; Bhardwaj, N.K. Suitability of corn stalk pulp for improving physical strength properties of agro-residue pulp. Cellul. Chem. Technol. 2020, 54, 65–71. [Google Scholar] [CrossRef]
- Fatriasari, W.; Supriyanto; Apri Heri, I. The Kraft Pulp And Paper Properties of Sweet Sorghum Bagasse (Sorghum bicolor L Moench). J. Eng. Technol. Sci. 2015, 47, 149–159. [Google Scholar] [CrossRef]
- Ferdous, T.; Quaiyyum, M.A.; Salam, A.; Jahan, M.S. Pulping of bagasse (Saccrarum officinarum), kash (Saccharum spontaneum) and corn stalks (Zea mays). Curr. Res. Green Sustain. Chem. 2020, 3, 100017. [Google Scholar] [CrossRef]
- Han, J.S. Chemical composition of fibers. Pap. Compos. Agrobased Resour. 1997, 5, 83–134. [Google Scholar]
- Ogunkunle, A.; Oladele, F. Structural dimensions and paper making potentials of the wood in some Nigerian species of Ficus L. (Moraceae). Adv. Nat. Appl. Sci. 2008, 2, 103–111. [Google Scholar]
- Titi, A.G.; Oluwafemi, O.A. Investigation into Wood Vessels and Rays of Ficus exasperata (Vahl) for Industrial Utilization. Asian J. Appl. Sci. 2019, 12, 140–148. [Google Scholar] [CrossRef]
- Mannai, F.; Ammar, M.; Yanez, J.G.; Elaloui, E.; Moussaoui, Y. Cellulose fiber from Tunisian Barbary Fig “Opuntia ficus-indica” for papermaking. Cellulose 2016, 23, 2061–2072. [Google Scholar] [CrossRef]
- Soliman, A.; Shehata, M.; Ahmad, F.; Abdel-Atty, M. Evaluation of paper pulp and paper making characteristics produced from different African woody trees grown in Egypt. Res. J. 2017, 11, 19–27. [Google Scholar] [CrossRef][Green Version]
- Salem, M.Z.M.; Abo Elgat, W.A.A.; Taha, A.S.; Fares, Y.G.D.; Ali, H.M. Impact of Three Natural Oily Extracts as Pulp Additives on the Mechanical, Optical, and Antifungal Properties of Paper Sheets Made from Eucalyptus camaldulensis and Meryta sinclairii Wood Branches. Materials 2020, 13, 1292. [Google Scholar] [CrossRef]
- López, F.; Ariza, J.; Pérez, I.; Jiménez, L. Influence of the operating conditions on the properties of paper sheets obtained by kraft pulping of olive tree wood. Bioresour. Technol. 2000, 72, 147–151. [Google Scholar] [CrossRef]
- İstek, A.; Özkan, İ. Effect of sodium borohydride on Populus tremula L. kraft pulping. Turk. J. Agric. For. 2008, 32, 131–136. [Google Scholar]
- Santos, R.B.; Capanema, E.A.; Balakshin, M.Y.; Chang, H.-m.; Jameel, H. Lignin Structural Variation in Hardwood Species. J. Agric. Food Chem. 2012, 60, 4923–4930. [Google Scholar] [CrossRef]
- Antes, R.; Joutsimo, O.P. Fiber surface and paper technical properties of Eucalyptus globulus and Eucalyptus nitens pulps after modified cooking and bleaching. BioResources 2015, 10, 1599–1616. [Google Scholar] [CrossRef]
- Santos, J.I.; Fillat, Ú.; Martín-Sampedro, R.; Eugenio, M.E.; Negro, M.J.; Ballesteros, I.; Rodríguez, A.; Ibarra, D. Evaluation of lignins from side-streams generated in an olive tree pruning-based biorefinery: Bioethanol production and alkaline pulping. Int. J. Biol. Macromol. 2017, 105, 238–251. [Google Scholar] [CrossRef]
- Mansfield, S.D.; Weineisen, H. Wood Fiber Quality and Kraft Pulping Efficiencies of Trembling Aspen (Populus tremuloides Michx) Clones. J. Wood Chem. Technol. 2007, 27, 135–151. [Google Scholar] [CrossRef]
- Deniz, İ.; Kırcı, H.; Ates, S. Optimisation of wheat straw Triticum drum kraft pulping. Ind. Crop. Prod. 2004, 19, 237–243. [Google Scholar] [CrossRef]
- Domínguez-Robles, J.; Sánchez, R.; Díaz-Carrasco, P.; Espinosa, E.; García-Domínguez, M.T.; Rodríguez, A. Isolation and characterization of lignins from wheat straw: Application as binder in lithium batteries. Int. J. Biol. Macromol. 2017, 104, 909–918. [Google Scholar] [CrossRef] [PubMed]
- de Andrés, M.Á.; Sequeiros, A.; Sánchez, R.; Requejo, A.; Rodríguez, A.; Serrano, L. Production of paper and lignin from Hesperaloe funifera. Environ. Eng. Manag. J. 2016, 15, 2479–2486. [Google Scholar]
- Domínguez-Robles, J.; Sánchez, R.; Espinosa, E.; Savy, D.; Mazzei, P.; Piccolo, A.; Rodríguez, A. Isolation and Characterization of Gramineae and Fabaceae Soda Lignins. International Journal of Molecular Sciences 2017, 18, 327. [Google Scholar] [CrossRef]
- Gominho, J.; Pereira, H. Influence of raw-material and process variables in the kraft pulping of Cynara cardunculus L. Ind. Crop. Prod. 2006, 24, 160–165. [Google Scholar] [CrossRef]
- Jiménez, L.; Angulo, V.; Ramos, E.; De la Torre, M.J.; Ferrer, J.L. Comparison of various pulping processes for producing pulp from vine shoots. Ind. Crop. Prod. 2006, 23, 122–130. [Google Scholar] [CrossRef]
- Dutt, D.; Upadhyay, J.S.; Singh, B.; Tyagi, C.H. Studies on Hibiscus cannabinus and Hibiscus sabdariffa as an alternative pulp blend for softwood: An optimization of kraft delignification process. Ind. Crop. Prod. 2009, 29, 16–26. [Google Scholar] [CrossRef]
- Mandal, S.; Marpu, S.B.; Hughes, R.; Omary, M.A.; Shi, S.Q. Green Synthesis of Silver Nanoparticles Using Cannabis sativa Extracts and Their Anti-Bacterial Activity. Green Sustain. Chem. 2021, 11, 38–48. [Google Scholar] [CrossRef]
- El-Hefny, M.; Mohamed, A.A.; Salem, M.Z.M.; Abd El-Kareem, M.S.M.; Ali, H.M. Chemical composition, antioxidant capacity and antibacterial activity against some potato bacterial pathogens of fruit extracts from Phytolacca dioica and Ziziphus spina-christi grown in Egypt. Sci. Hortic. 2018, 233, 225–232. [Google Scholar] [CrossRef]
- Salem, M.Z.M.; Ali, H.M.; Basalah, M.O. Essential oils from wood, bark, and needles of Pinus roxburghii Sarg. from Alexandria, Egypt: Antibacterial and antioxidant activities. BioResources 2014, 9, 7454–7466. [Google Scholar] [CrossRef]
- Salem, M.Z.M.; Zayed, M.Z.; Ali, H.M.; Abd El-Kareem, M.S.M. Chemical composition, antioxidant and antibacterial activities of extracts from Schinus molle wood branch growing in Egypt. J. Wood Sci. 2016, 62, 548–561. [Google Scholar] [CrossRef]
- Jin, S.; Li, K.; Gao, Q.; Zhang, W.; Chen, H.; Li, J.; Shi, S.Q. Multiple crosslinking strategy to achieve high bonding strength and antibacterial properties of double-network soy adhesive. J. Clean. Prod. 2020, 254, 120143. [Google Scholar] [CrossRef]
- Mandal, S.; Shi, S.Q. Agricultural Plants and Their Antimicrobial Activities—A Mini Review. Am. J. Biomed. Sci. Res. 2020, 11, 179–181. [Google Scholar] [CrossRef]
- Chen, Q.-Y.; Xiao, S.-L.; Shi, S.Q.; Cai, L.-P. A One-Pot Synthesis and Characterization of Antibacterial Silver Nanoparticle–Cellulose Film. Polymers 2020, 12, 440. [Google Scholar] [CrossRef]
- Li, Y.; Zhang, Y.; Wanru, D.; Yue, J.; Xu, M.; Shi, S.Q. Preparation and properties of pulp fibers treated with zinc oxide nanoparticles by in situ chemosynthesis. Holzforschung 2018, 72, 923–931. [Google Scholar] [CrossRef]
- Van Duong, D.; Missanjo, E.; Matsumura, J. Variation in intrinsic wood properties of Melia azedarach L. planted in northern Vietnam. J. Wood Sci. 2017, 63, 560–567. [Google Scholar] [CrossRef]
- El-Juhany, L.I. Evaluation of some wood quality measures of eight-year-old Melia azedarach trees. Turk. J. Agric. For. 2011, 35, 165–171. [Google Scholar]
- Matsumura, J.; Inoue, M.; Yokoo, K.; Oda, K. Cultivation and utilization of Japanese fast growing trees with high capability for carbon stock I. Potential of Melia azedarach. Mokuzai Gakkaishi J. Jpn. Wood Res. Soc. 2006, 52, 77–82. [Google Scholar] [CrossRef]
- Venson, I.; Silva Guzman, J.A.; Fuentes Talavera, F.J.; Richter, H.G. Biological, physical and mechanical wood properties of Paraíso (Melia azedarach) from a roadside planting at huaxtla, jalisco, mexico. J. Trop. For. Sci. 2008, 20, 38–47. [Google Scholar]
- Sharma, P.; Yelne, M.; Dennis, T. Data Base on Medicinal Plants Used in Ayurveda; Documentation & Publication Division, Central Council for Research in Ayurveda & Siddha: New Delhi, India, 2001; Volume III, p. 256. [Google Scholar]
- Rani, M.; Suhag, P.; Kumar, R.; Singh, R.; Kalidhar, S. Chemical components and biological efficacy of Melia azedarach Stems. J. Med. Aroma. Plant. Sci. 1999, 21, 1043–1047. [Google Scholar]
- Taylor, D.A.H. The Chemistry of the Limonoids from Meliaceae. In Fortschritte der Chemie Organischer Naturstoffe/Progress in the Chemistry of Organic Natural Products; Herz, W., Grisebach, H., Kirby, G.W., Eds.; Springer: Vienna, Austria, 1984; pp. 1–102. [Google Scholar]
- TAPPI. T 204 cm-07, Solvent Extractives of Wood and Pulp; TAPPI Press: Atlanta, GA, USA, 2007. [Google Scholar]
- TAPPI. T222 om-15, Acid-Insoluble Lignin in Wood and Pulp; TAPPI Press: Atlanta, GA, USA, 2015. [Google Scholar]
- TAPPI. T249-09, Carbohydrate Ition of Extractive-free Wood and Wood Pulp by Gas-liquid Chromatography; TAPPI Press: Atlanta, GA, USA, 2009. [Google Scholar]
- TAPPI. T211 om-16, Ash in Wood, Pulp, Paper and Paperboard: Combustion at 525 Degrees C; TAPPI Press: Atlanta, GA, USA, 2016. [Google Scholar]
- TAPPI. T 210 cm-03, Sampling and Testing Wood Pulp Shipments for Moisture; TAPPI Press: Atlanta, GA, USA, 2003. [Google Scholar]
- TAPPI. T625 cm-14, Analysis of Soda and Sulfate Black Liquor; TAPPI Press: Atlanta, GA, USA, 2014. [Google Scholar]
- TAPPI. T236 om-13, Kappa Number of Pulp; TAPPI Press: Atlanta, GA, USA, 2013. [Google Scholar]
- ISO. 5267-1:1999, Pulps—Determination of Drainability—Part 1: Schopper-Riegler Method. ISO: Geneva, Switzerland, 1999.
- TAPPI. T 425 om-16, Opacity of Paper (15/d Geometry, Illuminant A/2*, 89% Reflectance Backing and Paper Backing); TAPPI Press: Atlanta, GA, USA, 2016. [Google Scholar]
- TAPPI. T 452 OM-18, Brightness of Pulp, Paper, and Paperboard (Directional Reflectance at 457 nm); TAPPI Press: Atlanta, GA, USA, 2018. [Google Scholar]
- TAPPI. T 220 sp-16, Physical Testing of Pulp Handsheets; TAPPI Press: Atlanta, GA, USA, 2016. [Google Scholar]
- TAPPI. T 402 sp-08, Standard Conditioning and Testing Atmospheres for Paper, Board, Pulp Handsheets, and Related Products; TAPPI: Atlanta, GA, USA, 2008. [Google Scholar]
- TAPPI. T 205 sp-02, Forming Handsheets for Physical Tests of Pulp; TAPPI Press: Atlanta, GA, USA, 2002. [Google Scholar]
- TAPPI. T494 OM-13, Tensile Breaking Properties of Paper and Paperboard (Using Constant Rate of Elongation Apparatus); TAPPI Press: Atlanta, GA, USA, 2013. [Google Scholar]
- TAPPI. T414 OM-12, Internal Tearing Resistance of Paper (Elmendorf-Type Method); TAPPI Press: Atlanta, GA, USA, 2012. [Google Scholar]
- TAPPI. T 403 om-15, Bursting Strength of Paper; TAPPI Press: Atlanta, GA, USA, 2015. [Google Scholar]
- TAPPI. T 511 OM-02, Folding Endurance of Paper (MIT Tester); TAPPI Press: Atlanta, GA, USA, 2002. [Google Scholar]
- Hamad, Y.K.; Abobakr, Y.; Salem, M.Z.M.; Ali, H.M.; Al-Sarar, A.S.; Al-Zabib, A.A. Activity of plant extracts/essential oils against three plant pathogenic fungi and mosquito larvae: GC/MS analysis of bioactive compounds. BioResources 2019, 14, 4489–4511. [Google Scholar]
- Abdelkhalek, A.; Salem, M.Z.M.; Hafez, E.; Behiry, S.I.; Qari, S.H. The Phytochemical, Antifungal, and First Report of the Antiviral Properties of Egyptian Haplophyllum tuberculatum Extract. Biology 2020, 9, 248. [Google Scholar] [CrossRef]
- Al-Huqail, A.A.; Behiry, S.I.; Salem, M.Z.M.; Ali, H.M.; Siddiqui, M.H.; Salem, A.Z.M. Antifungal, Antibacterial, and Antioxidant Activities of Acacia Saligna (Labill.) H. L. Wendl. Flower Extract: HPLC Analysis of Phenolic and Flavonoid Compounds. Molecules 2019, 24, 700. [Google Scholar] [CrossRef]
- Ashmawy, N.A.; Salem, M.Z.M.; El Shanhorey, N.; Al-Huqail, A.; Ali, H.M.; Behiry, S.I. Eco-friendly wood-biofungicidal and antibacterial activities of various Coccoloba uvifera L. leaf extracts: HPLC analysis of phenolic and flavonoid compounds. BioResources 2020, 15, 4165–4187. [Google Scholar]
- Behiry, S.I.; Okla, M.K.; Alamri, S.A.; El-Hefny, M.; Salem, M.Z.M.; Alaraidh, I.A.; Ali, H.M.; Al-Ghtani, S.M.; Monroy, J.C.; Salem, A.Z.M. Antifungal and Antibacterial Activities of Musa paradisiaca L. Peel Extract: HPLC Analysis of Phenolic and Flavonoid Contents. Processes 2019, 7, 215. [Google Scholar] [CrossRef]
- El-Hefny, M.; Salem, M.Z.M.; Behiry, S.I.; Ali, H.M. The Potential Antibacterial and Antifungal Activities of Wood Treated with Withania somnifera Fruit Extract, and the Phenolic, Caffeine, and Flavonoid Composition of the Extract According to HPLC. Processes 2020, 8, 113. [Google Scholar] [CrossRef]
- Salem, M.Z.M.; Ibrahim, I.H.M.; Ali, H.M.; Helmy, H.M. Assessment of the Use of Natural Extracted Dyes and Pancreatin Enzyme for Dyeing of Four Natural Textiles: HPLC Analysis of Phytochemicals. Processes 2020, 8, 59. [Google Scholar] [CrossRef]
- Salem, M.Z.M.; Mansour, M.M.A.; Elansary, H.O. Evaluation of the effect of inner and outer bark extracts of sugar maple (Acer saccharum var. saccharum) in combination with citric acid against the growth of three common molds. J. Wood Chem. Technol. 2019, 39, 136–147. [Google Scholar] [CrossRef]
- SAS. Users Guide: Statistics (Release 8.02); SAS Institute Inc.: Cary, NC, USA, 2001. [Google Scholar]
- Belayachi, L.; Delmas, M. Sweet sorghum bagasse: A raw material for the production of chemical paper pulp.: Effect of depithing. Ind. Crop. Prod. 1997, 6, 229–232. [Google Scholar] [CrossRef]
- Belayachi, L.; Delmas, M. Sweet sorghum: A quality raw material for the manufacturing of chemical paper pulp. Biomass Bioenergy 1995, 8, 411–417. [Google Scholar] [CrossRef]
- Chen, Y.; Wu, Q.; Huang, B.; Huang, M.; Ai, X. Isolation and characteristics of cellulose and nanocellulose from lotus leaf stalk agro-wastes. BioResources 2015, 10, 684–696. [Google Scholar] [CrossRef]
- Li, M.; Wang, L.-j.; Li, D.; Cheng, Y.-L.; Adhikari, B. Preparation and characterization of cellulose nanofibers from de-pectinated sugar beet pulp. Carbohydr. Polym. 2014, 102, 136–143. [Google Scholar] [CrossRef]
- Khristova, P.; Kordsachia, O.; Daffalla, S. Alkaline pulping of Acacia seyal. Trop. Sci. 2004, 44, 207–215. [Google Scholar] [CrossRef]
- Moradbak, A.; Tahir, P.M.; Mohamed, A.Z.; Halis, R.B. Alkaline sulfite anthraquinone and methanol pulping of bamboo (Gigantochloa scortechinii). BioResources 2016, 11, 235–248. [Google Scholar] [CrossRef]
- Li, G.; Fu, S.; Zhou, A.; Zhan, H. Improved cellulose yield in the production of dissolving pulp from bamboo using acetic acid in prehydrolysis. BioResources 2015, 10, 877–886. [Google Scholar] [CrossRef]
- López, F.; Ariza, J.; Eugenio, M.E.; Díaz, J.; Pérez, I.; Jiménez, L. Pulping and bleaching of pulp from olive tree residues. Process. Biochem. 2001, 37, 1–7. [Google Scholar] [CrossRef]
- Díaz, M.J.; Eugenio, M.E.; López, F.; Alaejos, J. Paper from olive tree residues. Ind. Crop. Prod. 2005, 21, 211–221. [Google Scholar] [CrossRef]
- Caparrós, S.; Díaz, M.J.; Ariza, J.; López, F.; Jiménez, L. New perspectives for Paulownia fortunei L. valorisation of the autohydrolysis and pulping processes. Bioresour. Technol. 2008, 99, 741–749. [Google Scholar] [CrossRef] [PubMed]
- Kpikpi, W.; Olatunji, A. Wood anatomy consideration in deciding the suitability of some Nigerian Hardwoods for pulp and paper production. Niger. J. Bot. 1990, 3, 137–150. [Google Scholar]
- Taha, A.S.; Abo Elgat, W.A.A.; Fares, Y.G.D.; Dessoky, E.S.; Behiry, S.I.; Salem, M.Z.M. Using Plant Extractives as Eco-friendly Pulp Additives: Mechanical and Antifungal Properties of Paper Sheets Made from Linen Fibers. BioResources 2021, 16, 2589–2606. [Google Scholar] [CrossRef]
- Aoudia, H.; Ntalli, N.; Aissani, N.; Yahiaoui-Zaidi, R.; Caboni, P. Nematotoxic Phenolic Compounds from Melia azedarach Against Meloidogyne incognita. J. Agric. Food Chem. 2012, 60, 11675–11680. [Google Scholar] [CrossRef]
- M’rabet, Y.; Rokbeni, N.; Cluzet, S.; Boulila, A.; Richard, T.; Krisa, S.; Marzouki, L.; Casabianca, H.; Hosni, K. Profiling of phenolic compounds and antioxidant activity of Melia azedarach L. leaves and fruits at two stages of maturity. Ind. Crop. Prod. 2017, 107, 232–243. [Google Scholar] [CrossRef]
- Carpinella, M.C.; Giorda, L.M.; Ferrayoli, C.G.; Palacios, S.M. Antifungal Effects of Different Organic Extracts from Melia azedarach L. on Phytopathogenic Fungi and Their Isolated Active Components. J. Agric. Food Chem. 2003, 51, 2506–2511. [Google Scholar] [CrossRef] [PubMed]
- Kumazawa, S.; Kubota, S.; Yamamoto, H.; Okamura, N.; Sugiyama, Y.; Kobayashi, H.; Nakanishi, M.; Ohta, T. Antiangiogenic Activity of Flavonoids from Melia azedarach. Nat. Prod. Commun. 2013, 8. [Google Scholar] [CrossRef]
- Van der Nat, J.; Van der Sluis, W.; Van Dijk, H.; De Silva, K.; Labadie, R. Activity-guided isolation and identification of Azadirachta indica bark extract constituents which specifically inhibit chemiluminescence production by activated human polymorphonuclear leukocytes. Planta Med. 1991, 57, 65–68. [Google Scholar] [CrossRef]
- Rao, M.M.; Gupta, P.S.; Krishna, E.M.; Singh, P.P. Constituents of heartwood of Soymida febrifuga—Isolation of flavonoids. Ind. J. Chem. 1979, 17, 178–180. [Google Scholar]
Publisher’s Note: MDPI stays neutral with regard to jurisdictional claims in published maps and institutional affiliations. |
© 2021 by the authors. Licensee MDPI, Basel, Switzerland. This article is an open access article distributed under the terms and conditions of the Creative Commons Attribution (CC BY) license (https://creativecommons.org/licenses/by/4.0/).